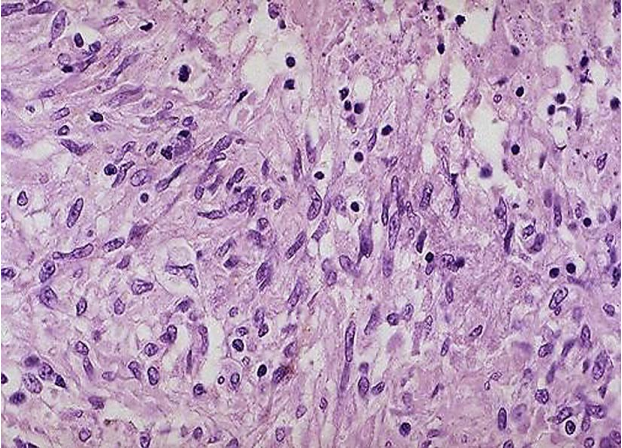
微信图片_20200201114959.png

•病原体为结核杆菌,血行传播为最主要的传播途径。
•常见临床表现为不孕、月经失调、下腹坠痛及发热、盗汗等全身症状。
•临床诊断较为困难,根据结核病史、临床表现及辅助检查进行诊断。
•治疗主要为抗结核药物治疗,必要时手术治疗。
由结核分枝杆菌引起的女性生殖器炎症,称为生殖器结核(genital tuberculosis),又称结核性盆腔炎。多见于20~40岁妇女,也可见于绝经后的老年妇女。近年因耐多药结核、艾滋病的增加以及对结核病控制的松懈,生殖器结核发病率有升高趋势。一旦确诊为生殖器结核,应转诊至结核病专科医院治疗。
【传染途径】
生殖器结核是全身结核的表现之一,常继发于身体其他部位结核如肺结核、肠结核、腹膜结核等,约10%肺结核患者伴有生殖器结核。生殖器结核潜伏期很长,可达1~10年,多数患者在日后发现生殖器结核时,其原发病灶多已痊愈。生殖器结核常见的传染途径:
1.血行传播 为最主要的传播途径。青春期时正值生殖器发育,血供丰富,结核菌易借血行传播。结核杆菌感染肺部后,大约1年内可感染内生殖器,由于输卵管黏膜有利于结核菌的潜伏感染,结核杆菌首先侵犯输卵管,然后依次扩散到子宫内膜、卵巢,侵犯宫颈、阴道、外阴者较少。
2.直接蔓延 腹膜结核、肠结核可直接蔓延到内生殖器。
3.淋巴传播 较少见。消化道结核可通过淋巴管传播感染内生殖器。
4.性交传播 极罕见。男性患泌尿系结核,通过性交传播,上行感染。
【病理】
1.输卵管结核 占女性生殖器结核的90%~100%,即几乎所有的生殖器结核均累及输卵管,双侧性居多,但双侧的病变程度可能不同。输卵管增粗肥大,其伞端外翻如烟斗嘴状是输卵管结核的特有表现;也可表现为伞端封闭,管腔内充满干酪样物质;有的输卵管增粗,管壁内有结核结节;有的输卵管僵直变粗,峡部有多个结节隆起。输卵管浆膜面可见多个粟粒结节,有时盆腔腹膜、肠管表面及卵巢表面也布满类似结节,或并发腹腔积液型结核性腹膜炎。在输卵管管腔内见到干酪样物质,有助于同非结核性炎症相鉴别。输卵管常与其邻近器官如卵巢、子宫、肠曲广泛粘连。

输卵管结核表现
左侧输卵管僵直、变粗,浆膜面可见粟粒结节(箭头所指);右侧输卵管迂曲、增粗肥大;子宫
直肠陷窝可见少量淡黄色腹水。
2.子宫内膜结核 常由输卵管结核蔓延而来,占生殖器结核的50%~80%。输卵管结核患者约半数同时有子宫内膜结核。早期病变出现在宫腔两侧角,子宫大小、形状无明显变化,随着病情进展,子宫内膜受到不同程度结核病变破坏,最后代以瘢痕组织,可使宫腔粘连变形、缩小。
3.卵巢结核占生殖器结核的20%~30%,主要由输卵管结核蔓延而来,因有白膜包围,通常仅有卵巢周围炎,侵犯卵巢深层较少。少部分卵巢结核由血循环传播而致,可在卵巢深部形成结节及干酪样坏死性脓肿。
4.宫颈结核 常由子宫内膜结核蔓延而来或经淋巴或血循环传播,较少见,占生殖器结核的10%~20%。病变可表现为乳头状增生或为溃疡,这时外观易与子宫颈癌混淆。

宫颈结核
5.盆腔腹膜结核 盆腔腹膜结核多合并输卵管结核。根据病变特征不同分渗出型和粘连型。渗出型以渗出为主,特点为腹膜及盆腔脏器浆膜面布满无数大小不等的散在灰黄色结节,渗出物为浆液性草黄色澄清液体,积聚于盆腔,有时因粘连形成多个包裹性囊肿;粘连型以粘连为主,特点为腹膜增厚,与邻近脏器之间发生紧密粘连,粘连间的组织常发生干酪样坏死,易形成瘘管。
【临床表现】
依病情轻重、病程长短而异。有的患者无任何症状,有的患者则症状较重。
1.不孕 多数生殖器结核因不孕而就诊。在原发性不孕患者中生殖器结核为常见原因之一。由于输卵管黏膜破坏与粘连,常使管腔阻塞;或因输卵管周围粘连,有时管腔尚保持部分通畅,但黏膜纤毛被破坏,输卵管僵硬、蠕动受限,丧失运输功能;子宫内膜结核妨碍受精卵的着床与发育,也可致不孕。
2.月经失调 早期因子宫内膜充血及溃疡,可有经量过多;晚期因子宫内膜遭不同程度破坏而表现为月经稀少或闭经。多数患者就诊时已为晚期。
3.下腹坠痛 由于盆腔炎性疾病症和粘连,可有不同程度的下腹坠痛,经期加重。
4.全身症状 若为活动期,可有结核病的一般症状,如发热、盗汗、乏力、食欲缺乏、体重减轻等。轻者全身症状不明显,有时仅有经期发热,但症状重者可有高热等全身中毒症状。
5.全身及妇科检查由 于病变程度与范围不同而有较大差异,较多患者因不孕行诊断性刮宫、子宫输卵管碘油造影及腹腔镜检查才发现患有盆腔结核,而无明显体征和其他自觉症状。严重盆腔结核常合并腹膜结核,检查腹部时有柔韧感或腹腔积液征,形成包裹性积液时,可触及囊性肿块,边界不清,不活动,表面因有肠管粘连,叩诊空响。子宫一般发育较差,往往因周围有粘连使活动受限。若附件受累,在子宫两侧可触及条索状的输卵管或输卵管与卵巢等粘连形成的大小不等及形状不规则的肿块,质硬、表面不平,呈结节状突起,或可触及钙化结节。
【诊断】
多数患者缺乏明显症状,阳性体征不多,故诊断时易被忽略。为提高确诊率,应详细询问病史,尤其当患者有原发不孕、月经稀少或闭经时;未婚女青年有低热、盗汗、盆腔炎性疾病或腹腔积液时;既往有结核病接触史或本人曾患肺结核、胸膜炎、肠结核时,均应考虑有生殖器结核的可能。下列辅助检查方法,可协助诊断。若能找到病原学或组织学证据即可确诊。常用的辅助诊断方法如下:
1.子宫内膜病理检查 是诊断子宫内膜结核最可靠的依据。由于经前子宫内膜较厚,若有结核菌,此时阳性率高,故应选择在经前1周或月经来潮6小时内行刮宫术。术前3日及术后4日应每日肌内注射链霉素0.75g及口服异烟肼0.3g,以预防刮宫引起结核病灶扩散。由于子宫内膜结核多由输卵管蔓延而来,故刮宫时应注意刮取子宫角部内膜,并将刮出物送病理检查,在病理切片上找到典型结核结节,诊断即可成立,但阴性结果并不能排除结核的可能。若有条件应将部分刮出物或分泌物作结核菌培养。遇有宫腔小而坚硬,无组织物刮出,结合临床病史及症状,也应考虑为子宫内膜结核,并作进一步检查。若宫颈可疑结核,应做活组织检查确诊。

结核结节

结核结节

子宫内膜结核病理
2.X线检查
(1)胸部X线摄片:必要时行消化道或泌尿系统X线检查,以便发现原发病灶。
(2)盆腔X线摄片:发现孤立钙化点,提示曾有盆腔淋巴结结核病灶。
(3)子宫输卵管碘油造影:可能见到下列征象:①宫腔呈不同形态和不同程度狭窄或变形,边缘呈锯齿状;②输卵管管腔有多个狭窄部分,呈典型串珠状或显示管腔细小而僵直;③在相当于盆腔淋巴结、输卵管、卵巢部位有钙化灶;④若碘油进入子宫一侧或两侧静脉丛,应考虑有子宫内膜结核的可能。子宫输卵管造影对生殖器结核的诊断帮助较大,但也有可能将输卵管管腔中的干酪样物质及结核菌带到腹腔,故造影前后应肌内注射链霉素及口服异烟肼等抗结核药物。

输卵管通畅

输卵管串珠样改变
3.腹腔镜检查 能直接观察子宫、输卵管浆膜面有无粟粒结节,并可取腹腔液行结核菌培养,或在病变处做活组织检查。做此项检查时应注意避免肠道损伤。
4.结核菌检查 取月经血或宫腔刮出物或腹腔液作结核菌检查,常用方法:①涂片抗酸染色查找结核菌;②结核菌培养,此法准确,但结核菌生长缓慢,通常1~2个月才能得到结果;③分子生物学方法,如PCR技术,方法快速、简便,但可能出现假阳性;④动物接种,方法复杂,需时较长,难以推广。

结核菌抗酸染色
5.结核菌素试验 结核菌素试验阳性说明体内曾有结核分枝杆菌感染,若为强阳性说明目前仍有活动性病灶,但不能说明病灶部位,若为阴性一般情况下表示未有过结核分枝杆菌感染。

结核菌素试验注射方法

结核菌素试验结果
表20-3 结核菌素试验结果判定

6.γ-干扰素释放实验(interferon gamma release assays, IGRAS) 是诊断结核病的新方法,其原理是当体内曾经受到结核杆菌抗原刺激而致敏的T淋巴细胞再次遇到同类抗原时能产生γ-干找素,可通过检测γ-干扰素浓度或从单细胞水平检测分泌γ-干扰素细胞数目来诊断肺结核及肺外结核,具有很高的敏感性和特异性。
7.其他 白细胞计数不高,分类中淋巴细胞增多,不同于化脓性盆腔炎性疾病;活动期红细胞沉降率增快,但正常不能除外结核病变,这些化验检查均为非特异性,只能作为诊断参考。
【鉴别诊断】
结核性盆腔炎性疾病应与盆腔炎性疾病后遗症、子宫内膜异位症、卵巢恶性肿瘤,尤其是卵巢上皮性癌鉴别,诊断困难时,可作腹腔镜检查或剖腹探查确诊。
【治疗】
采用抗结核药物治疗为主,休息营养为辅的治疗原则。
1.抗结核药物治疗 抗结核药物治疗对90%女性生殖器结核有效。药物治疗应遵循早期、联合、规律、适量、全程的原则。采用异烟肼、利福平、乙胺丁醇及吡嗪酰胺等抗结核药物联合治疗6~9个月,可取得良好疗效。推荐两阶段短疗程药物治疗方案,前2~3个月为强化期,后4~6个月为巩固期或继续期。2010年WHO结核病诊疗指南指出生殖器结核的抗结核药物的选择、用法、疗程参考肺结核病。常用的治疗方案:①强化期2个月,每日异烟肼、利福平、吡嗪酰胺及乙胺丁醇四种药物联合应用,后4个月巩固期每日连续应用异烟肼、利福平(简称2 HRZE/4HR);或巩固期每周3次间歇应用异烟肼、利福平(2HRZE/4H3R3)。②强化期每日异烟肼、利福平、吡嗪酰胺、乙胺丁醇四种药联合应用2个月,巩固期每日应用异烟肼、利福平、乙胺丁醇连续4个月(2HRZE/4HRE);或巩固期每周3次应用异烟肼、利福平、乙胺丁醇连续4个月(2HRZE/4H3R3E3)。第一个方案可用于初次治疗的患者,第二个方案多用于治疗失败或复发的患者。
2.支持疗法 急性患者至少应休息3个月,慢性患者可以从事部分工作和学习,但要注意劳逸结合,加强营养,适当参加体育锻炼,增强体质。
3.手术治疗 出现以下情况应考虑手术治疗:①盆腔包块经药物治疗后缩小,但不能完全消退;②治疗无效或治疗后又反复发作者,或难以与盆腹腔恶性肿瘤鉴别者;③盆腔结核形成较大的包块或较大的包裹性积液者;④子宫内膜结核严重,内膜破坏广泛,药物治疗无效者。为避免手术时感染扩散,提高手术后治疗效果,手术前后需应用抗结核药物治疗。手术以全子宫及双侧附件切除术为宜。对年轻妇女应尽量保留卵巢功能;对病变局限于输卵管,而又迫切希望生育者,可行双侧输卵管切除术,保留卵巢及子宫。由于生殖器结核所致的粘连常较广泛而紧密,术前应口服肠道消毒药物并作清洁灌肠,术时应注意解剖关系,避免损伤。
虽然生殖器结核经药物治疗取得良好疗效,但治疗后的妊娠成功率极低,对部分希望妊娠者,可行辅助生育技术助孕。
【预防】
增强体质,做好卡介苗接种,积极防治肺结核、淋巴结结核和肠结核等。
(薛凤霞)


